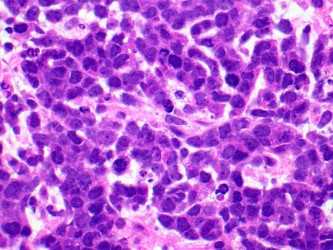

Case History
A 67-year old woman with a history of bilateral breast cancer (2000), cervical cancer (1980) and recently diagnosed diffuse large B cell lymphoma admitted for chemotherapy. Pretreatment work-up showed increased serum creatinine of 6.7 mg per dL (baseline 1.0). Renal biopsy showed diffuse interstitial edema associated with diffuse expansile interstitial cellular infiltrate associated with frequent mitosis and apoptosis and acute tubular injury with tubulitis (Fig a, b & c). No glomerular lesions were present. Immunofluorescence and electron microscopy studies were unremarkable.
Which of the following is most appropriate initial immunohistochemical panel for the diagnosis?
- CD20, CD3 and Pan-CK
- CD20, LCA and GATA-3
- LCA, GATA and p16
- CD20, Ki67 and Pan-CK

Answer: CD20, CD3 and Pan-CK
Brief explanation of the answer:
In view of clinical history, the differential diagnosis included renal involvement by B-Cell lymphoma vs metastatic carcinoma. Therefore, given the choices panel, 1 seems to be the most suitable for differentiating cells of lymphoid vs epithelial origin. The interstitial cells showed strong diffuse positivity for CD20 (Fig d) and no staining for pan-CK, diagnostic of renal parenchymal involvement by B-cell lymphoma. Also the cytological features i.e., monomorphic cells with high N/C ratio and fine chromatin, favor lymphoma and are typically not seen with adenocarcinoma (breast) and squamous cell carcinoma (cervix).
Lymphocytic infiltration of kidney parenchyma occurs commonly in lymphoma patients. However, it is an under-recognized complication as shown by the largest case series of autopsies performed on lymphoma patients where 34% showed parenchymal invasion, but only 14% had been diagnosed before the time of death. This discrepancy is attributed not only to the absence of clinical signs but also to the diversity of lymphoma-related renal manifestations that makes diagnosis difficult.
Renal dysfunction primarily due to lymphomatous or leukemic infiltration is not uncommon and varies from asymptomatic to severe and requires renal replacement therapy. However, acute renal failure, as seen in this patient, from infiltration is seen in <1% of cases of all patients with lymphomas and correlates with the extent of interstitial involvement. It is postulated that renal failure resulting from infiltration is secondary to acute tubular compression and disruption of the kidney microvasculature from increased interstitial pressure leading to acute kidney injury.
Although only limited data is available, it seems like renal response in these patients not only relies on hematologic response but is also related to the subtype of lymphoma, concurrent glomerular disease, and preexisting chronic kidney injury. Therefore, complete recovery to baseline function is infrequent. Moreover, the presence of metastatic lymphoma in the kidney indicates advanced disease and carries an overall poor prognosis.
References:
Corlu, et al. Renal Dysfunction in Patients With Direct Infiltration by B-Cell Lymphoma. Kidney Int Rep (2019) 4, 688–697; https://doi.org/10.1016/j.ekir.2019.02.008
Luciano, et al. Kidney Involvement in Leukemia and Lymphoma. Advances in Chronic Kidney Disease, Vol 21, No 1 (January), 2014: pp 27-35
Cohen, et al. The Spectrum of Kidney Involvement in Lymphoma: a Case Report and Review of the Literature. Am J Kidney Dis. 2010 December ; 56(6): 1191–1196. doi:10.1053/j.ajkd.2010.07.009.